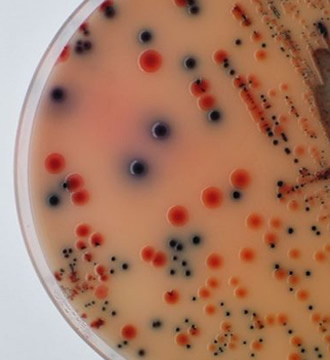
thumbnail

Postedo por Ahecro
 Contador Hematologico
Contador Hematologico
COUNTER 29 - 5 diff - 60 muestras por hora
coninuar leyendo
Postedo por Ahecro
 BACTEC MGIT 320 System
BACTEC MGIT 320 System
Sistema para el Cultivo de Micobacterias
Tiempo minimo de manipulacion y de
coninuar leyendo
Postedo por Ahecro
 BD MAX INSTRUMENT
BD MAX INSTRUMENT
Diagnostico molecular en 1 SOLO EQUIPO de sobremesada
Equipo ABIERTO para PCR en
coninuar leyendo
Postedo por Ahecro
 BD Veritor Plus Analyzer Equipo lector
BD Veritor Plus Analyzer Equipo lector
Influenza A+B
Virus respiratorio sincicial (RSV)
coninuar leyendo
Postedo por Ahecro
 Contador hematologico automatico Counter XS20, 40 test/hora. 3 diff.
Contador hematologico automatico Counter XS20, 40 test/hora. 3 diff.
Venta.
Alquiler o Comodat
coninuar leyendo
Postedo por Ahecro
 Contador Hematologico.
Contador Hematologico.
COUNTER 31 - 5 diff - Hasta 60 muestras por hora con cargador automatico
Hasta
coninuar leyendo

Contador Hematologico
Contador Hematologico
 BACTEC MGIT 320 System
BACTEC MGIT 320 System
 BD MAX INSTRUMENT
BD MAX INSTRUMENT
 BD Veritor Plus Analyzer Equipo lector
BD Veritor Plus Analyzer Equipo lector
 Contador hematologico automatico Counter XS20, 40 test/hora. 3 diff.
Contador hematologico automatico Counter XS20, 40 test/hora. 3 diff.
 Contador Hematologico.
Contador Hematologico.